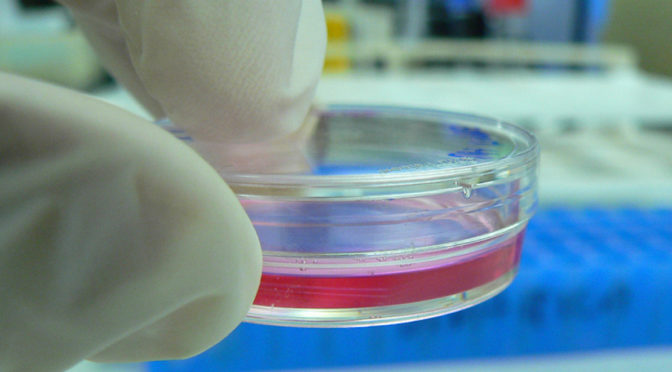
Computer vision saves lives

Australia’s renewable resources include wind, solar, wave and geothermal energy, and there’s significant research happening to improve generation and storage technologies to overcome the inherent disadvantage of intermittent flow.
The Australian Renewable Energy Agency (ARENA) has completed 32 projects and is managing more than 200 others, including several large-scale solar photovoltaic (PV) plants and wind farms, which are considered the most advanced technologies in terms of making a short-term impact on our renewable electricity generation.
Australia’s CRC for Renewable Energy (ACRE), which operated 1996–2004, developed a state-of-the-art facility for testing grid-connected renewable energy systems, as well as small-capacity wind turbines for remote generation.
Australian scientists at the CRC for Polymers (CRC-P) have made big strides in the development of flexible, lightweight solar cells, which CEO Dr Ian Dagley describes as the “antithesis” of rigid rooftop solar cells. These lightweight cells offer intriguing possibilities: their flexibility means they can be placed on a variety of surfaces, from walls to windows, and they can operate indoors to help charge electrical devices.
They’re also attractive because they’re considerably cheaper to manufacture than silicon solar cells. Dagley says his CRC-P team has been working on refining the manufacturing technique, which uses low-cost components and reel-to-reel printers. One of the goals is to increase the lifespan of the cells, which is about five years, whereas rigid cells last roughly 30 years.
Meanwhile, the CRC for Low Carbon Living (CRCLCL) is looking at ways to dramatically reduce greenhouse gas emissions by developing smarter, more energy efficient buildings and cities. CEO Dr Deo Prasad says lower carbon buildings can be realised by optimising design to ensure maximum energy efficiency, through integration of next-generation technologies, such as solar PV cladding and heat and electricity capture systems for on-site energy offsets, and by using more sustainable building materials that need less energy to extract, process and manufacture. At the suburb and city scale, Prasad says decentralised renewable energy generation, reliable storage and smart grids, linked with information and communications technology-based intelligence, will lower carbon impacts.
“We recognise there is not going to be a silver bullet solution to carbon reductions,” says Prasad. “The approach needs to be holistic and driven by industry and governments.”
There are challenges associated with increased renewable energy levels, but Australia’s National Electricity Market seems to be handling integration well so far, says Dr Iain MacGill, joint director of the UNSW Centre for Energy and Environmental Markets. Studies by the Australian Energy Market Operator show it’s possible to operate the national grid with 100% renewables. “It won’t be cheap – just a lot cheaper than unchecked climate change,” MacGill says.
Russell Marsh, director of policy for the Clean Energy Council, emphasises the importance of commitment. “Investors need long-term certainty to ensure a rate of return,” says Marsh. “The Federal Government needs to lock in a firm, long-term target.”
MacGill agrees that the right policies can incentivise investment, but adds that it requires leadership and social consensus. “Australia is contradictory on clean energy. We have an early history and remarkable success in renewable energy deployment, and fantastic renewable resources. But we are also among the world’s largest coal and gas exporters,” he says.
“Will we take a leadership role, or do all we can to keep our international coal and gas customers buying from us?”

Remodelling energy
While coal and gas continue to be our dominant energy sources, the once-burgeoning renewables industry has been hindered by the Federal Government’s recent review of the Renewable Energy Target (RET). The review recommended scrapping the 20% target for renewable electricity generation by 2020, resulting in political deadlock and investor uncertainty across the renewable energy sector.
Bloomberg New Energy Finance’s Australian head, Kobad Bhavnagri, says the review was especially damaging because it came “very close to making retroactive changes to a policy”.
“Whenever retroactive changes are made to policy it becomes, essentially, Ebola for investors,” he says. “When governments act unpredictably and destroy the value of existing assets, it scares people – for a long time.”
Australia generates more carbon emissions per person than any other OECD country. One-third are generated by the electricity sector, in which coal and natural gas account for roughly 85% of generating capacity. Renewables, mostly from hydropower, account for about 15%.
Reaching the 20% target during the next five years will not be cheap. At the time of the review it was estimated that another $18 billion of investment would be required to reach the target.
But the costs associated with increased generating capacity are yet to be weighed against the costs of potentially catastrophic climate change. Scientists have warned a 2°C increase in overall average temperatures from pre-industrial levels is the limit our planet can withstand before the effects of climate change become irreversible.
In December 2014, following the release by the International Energy Agency (IEA) of its report World Energy Outlook 2015, the agency’s chief economist and director of global energy economics, Dr Fatih Birol, told Bloomberg’s Business Week that global investment in renewable energy needs to quadruple to a yearly average of $1.6 trillion until at least 2040, to stay below that warming threshold.
Some of the world’s biggest economies have taken note. Estimates by the Climate Interactive indicate the US-China emissions deal, if implemented in full, could keep some 580 billion tonnes of CO2 out of the atmosphere between now and 2030 – more than all global fossil fuel emissions from 1990 to 2013.
In 2014 – while China spent US$64 billion on large-scale clean energy projects, increasing its 2013 total by about US$10 billion – the USA spent nearly US$13 billion on utility-scale renewables and continued to expand production of its almost carbon-neutral shale gas reserves (see here for Australia’s progress).
Research by Bloomberg New Energy Finance found Australian investment in large-scale renewable energy in 2014 was US$223 million – the lowest in more than a decade. 2014 saw Australia nose-dive from 11th largest investor in commercial clean energy projects to 39th, behind developing nations such as Honduras and Myanmar.
The 2040 outlook
If Australia is serious about boosting its capacity for renewable energy, 2040 is a good deadline, says Iain MacGill, joint director (engineering) for the Centre for Energy and Environmental Markets at UNSW Australia – by then we’ll need “a major infrastructure transition”.
Russell Marsh is Director of Policy for the Clean Energy Council, the peak body representing Australia’s clean energy sector. “With the right level of support we could see the deployment of renewable energy at least double between 2020–2040,” he says. “But if the target is not extended beyond 2020, it is unlikely that we will see further growth.”
This view is backed by the Australian government’s Bureau of Resources and Energy Economics (BREE). In a November 2014 report looking towards mid-century electricity production, it reported “In the absence of potential new policy initiatives, the relative shares of fossil fuels and renewables in electricity generation are not likely to change significantly”.
In fact, BREE’s projections show renewable generating capacity remaining stable, meeting 20% of Australia’s total demand from 2020–2050. In this scenario, coal-fired power would still account for 65% of electricity by mid-century.
There are concerns that the current policy uncertainty is reaching a tipping point, which could see companies exiting Australia or going into distress.

Policy uncertainty is taking a toll on the business end of renewable energy.
In July 2014, RenewEconomy reported that Recurrent Energy, a US solar power plant developer being acquired by Canadian Solar, was planning to cease its Australian operations, citing concerns over policy uncertainty. Several other large international renewable energy companies, including Spain’s Acciona and US-based First Solar, have warned of possible exits, should the Renewable Energy Target be amended.
MacGill says exits are inevitable. “Why would an internationally focused renewable energy company stay if there is no prospect for their projects to go forward?
“They can, should and will depart at some point,” he says. “And with their departure, we will lose institutional capacity – such as people, money and industrial knowhow – which will inevitably
slow our ability to deploy clean energy, and increase its costs.”
Marsh agrees the risk to the industry is significant. “Every day, week and month that goes by with a cloud hanging over support for the renewable energy industry are days, weeks and months when our international competitors are racing ahead of us – and reaping billions of dollars in investment in this global growth market.”
Dr Deo Prasad, CEO of the CRC for Low Carbon Living, says that while the effects aren’t as dramatic, policy uncertainty also impacts the research community, especially “end-user driven projects where collaboration is essential”.
“Many a research direction and focus has had to change over the years, for the worse, due to policy uncertainty,” he adds.
– Myles Gough
CRC for Low Carbon Living
CRC for Polymers (CRC-P)